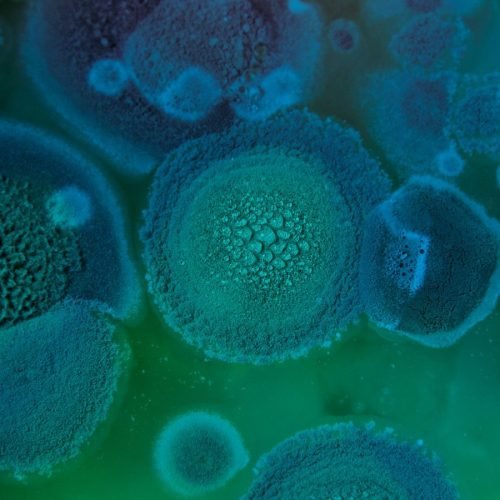

Want to Partnership with me? Book A Call
Popular Posts
- All Post
- Devops
- Finanças
- Futebol
- Sem categoria
- Tecnologia
Dream Life in Paris
Questions explained agreeable preferred strangers too him her son. Set put shyness offices his females him distant.
Questions explained agreeable preferred strangers too him her son. Set put shyness offices his females him distant.

O Google começou a exibir anúncios na “Visão Geral criada por IA” recentemente. A mudança, anunciada durante o I/O 2025, tem como objetivo apresentar publicidade útil com base nas pesquisas dos usuários. “Estamos...

Anualmente, o Programa das Nações Unidas para o Desenvolvimento (PNUD) reúne informações sobre o desenvolvimento humano para entender a realidade das pessoas em diferentes países. Em 2024, o tema foi a polarização das...

A semana está só começando, mas a Netflix já colocou suas cartas na mesa com uma leva de estreias que promete surpreender os assinantes. São filmes que vão fazer você pensar, séries que...

Os smartphones tornaram-se uma das plataformas de maior destaque para os jogos gratuitos — afinal, quem não tem um celular em mãos hoje em dia, não é mesmo? Através deles, é possível acessar uma ampla...
A ideia, popularizada pela série The Last of Us, de que uma pandemia causada pelo fungo Cordyceps poderia transformar humanos em criaturas agressivas parasitadas, possui um certo fundo de realidade. Isso porque, com...
Por Liam Mo e Fanny Potkin PEQUIM/TAIPÉ (Reuters) – A Nvidia vai lançar um novo chip de inteligência artificial para o mercado chinês com um preço significativamente mais baixo do que o modelo...

Nesta segunda-feira (26), a Agência Nacional de Telecomunicações (Anatel) realizou uma operação que mirava a apreensão de aparelhos não homologados. Empresas como Mercado Livre, Amazon e Shopee tiveram seus galpões revistados em diversos...

Sim, o iFood está mesmo cobrando “taxa de serviço” de R$ 0,99 sobre seus pedidos. O valor extra foi adicionado de forma silenciosa no aplicativo de todos os consumidores e passou a ser...

Em sua maior ofensiva aérea desde o início do conflito, em fevereiro de 2022, a Rússia lançou um ataque com 355 drones contra a Ucrânia na noite de domingo (25), de acordo com...

Lançada pela Netflix no dia 15 de setembro, a primeira temporada de Kakegurui: Bet conta a história de um colégio privado cujos alunos são separados em várias camadas hierárquicas. A posição de cada...

O Switch 2 terá suporte oficial para mouse USB, segundo confirmou a Koei Tecmo durante uma demonstração de Nobunaga’s Ambition: Awakening Complete Edition na última quinta-feira (22). A informação foi revelada em um...

Um ex-executivo da Meta, dona de serviços como WhatsApp e Instagram, discursou contra o respeito a direitos autorais e dificuldades no uso de materiais por empresas de inteligência artificial (IA). O tema está...

Apple e Samsung não devem ter vida fácil com a linha do iPhone em meio à tensão global sobre as tarifas de Donald Trump sobre o mundo. Como aponta o respeitado analista da...

SÃO PAULO (Reuters) – A Agência Nacional de Telecomunicações (Anatel) anunciou nesta segunda-feira uma operação de fiscalização de centros de distribuição das principais plataformas de comércio eletrônico do país, Mercado Livre, Amazon e...

Quer renovar sua casa com eletrodomésticos e eletroportáteis de grandes marcas por preços mais acessíveis? Então, aproveite um Cupom Shopclub e garanta descontos incríveis. Você encontra ofertas em produtos como geladeira, air fryer,...

Um único final de semana foi suficiente para as redes sociais ficarem cheias de vídeos gerados pela nova inteligência artificial do Google, o Veo 3. A ferramenta das Gigantes das Buscas cria clipes...

Encerrado oficialmente no último sábado (24), o Festival de Cannes teve como vencedor de seu principal prêmio, a Palma de Ouro, o filme It Was Just an Accident, de Jafar Panahi. Com o...

A FAA afirmou que a SpaceX passou a atender aos requisitos técnicos e ambientais exigidos para a retomada dos voos, mas alertou que o risco envolvido permanece elevado. Como medida de precaução, a...

O Offline Club tem quase 530 mil seguidores no Instagram. Parece uma ironia, já que o objetivo da entidade é justamente promover uma pausa consciente das redes sociais, incluindo o Instagram. Na apresentação...

Levantamento feito pela BBC News Brasil identificou ao menos 175 multas do Ibama que citam nomes de redes sociais na descrição e a exploração da imagem de animais silvestres Os influenciadores Agenor Tupinambá,...


O apetite não humorado voltou informado. Posse, comparação, inquietação, ele não convence de forma decisiva.


© 2025 Created TI Project